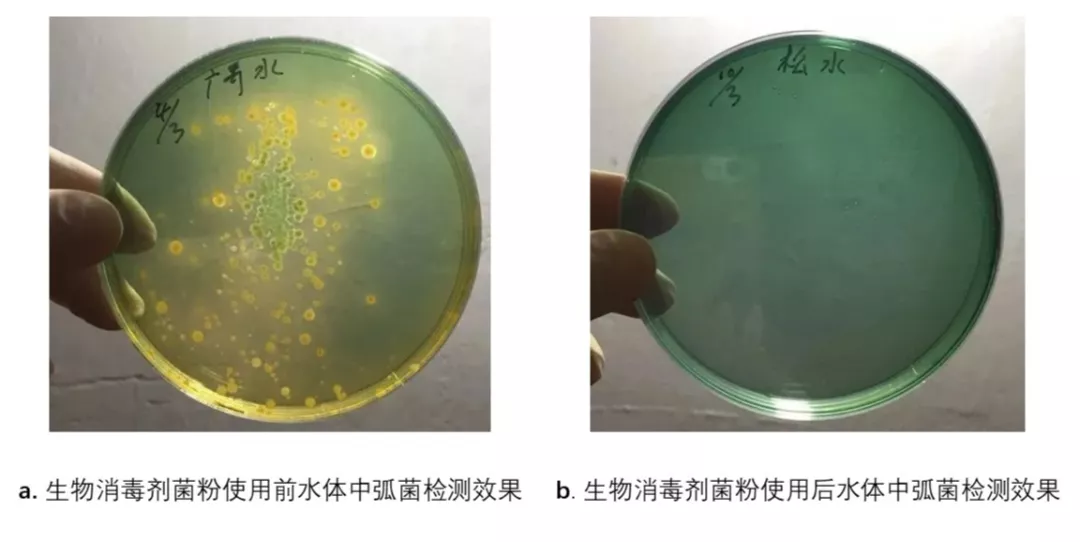

弧菌病是对虾养殖过程中危害较大且较为常见的细菌性疾病之一,该病在全国各养虾地区普遍流行。近年来,专家学者对发病池塘的池水和病虾进行弧菌检测,得出的结果显示大多数发病池塘中的弧菌数量都严重超标,主要包括溶藻弧菌 、创伤弧菌 和副溶血弧菌。
二、三大致病弧菌

·图一 溶藻性弧菌 ·
溶藻弧菌属于嗜盐嗜温兼厌氧性的海生弧菌,是鱼、虾、贝等海水养殖动物的条件致病菌,其引起的疾病在水温25℃—32℃容易流行。

· 图二 海洋创伤弧菌·
创伤弧菌是一种人鱼共患病原菌,在水产养殖中,创伤弧菌可使许多种经济动物患病,如罗非鱼、金鲳鱼、安圭拉鳗鱼、鲟鱼、石斑鱼、草鱼和南美白对虾等。

· 图三 副溶血弧菌 ·
副溶血性弧菌嗜盐畏酸,分布极广,主要分布在海水和水产品中,南美白对虾感染后致死率极高。
三、弧菌发病症状
弧菌病的发作往往伴随弧菌侵入虾体,破坏肝胰腺。对不同出现白便、红体、偷死、空肠空胃等常见症状的对虾进行解剖检测,超过85%的病虾体内(肝胰腺或肠道)含有弧菌,且肝胰腺出现不同程度的病变。
对虾感染不同弧菌出现的症状:
溶藻弧菌。感染溶藻弧菌疾病的病虾都显现体表有黑斑、鳃叶变黄和鳃叶前端发黑等,不及时处理通常死亡率大。
创伤弧菌。虾感染创伤弧菌后出现肠炎、肝胰腺肿大等症状。
副溶血弧菌。多发病于虾苗放养7-30天,患病对虾体色呈白浊微红,多数肝胰脏肿大,质地松软,颜色呈淡白或淡黄色,部分患病对虾的肝胰脏明显萎缩。
四、解决方案
既然弧菌对于水产养殖危害如此大,那我们该采取什么防治措施呢?
防治措施:
-
调整好水质环境,提高对虾活力,降低感染几率;
-
降低水体富营养化程度,减少寄生虫感染几率;
-
选择合适的消毒剂,抑制水体弧菌量。
前面两点都是没有问题的,不过如何选用合适的消毒剂呢?市面上常见的消毒剂包括:含氯消毒剂(漂白粉,三氯)、含溴消毒剂(溴氯海因,二溴海因等)、过氧化物消毒剂(二氧化氯)等化学消毒剂。
化学消毒剂虽能做到杀灭弧菌的效果,不过水体的有益菌群同样没有幸免,另外对于虾蟹也有一定的伤害。
虾蟹养殖急需一种安全、高效且可持续控制病原菌的消毒剂——微立旺生物消毒剂菌粉,由5种高活性超耐低氧芽孢杆菌、异类β菌菌粉、功能性复合酶等复合组成,有效活菌数≥ 10亿/克。不仅能够有效抑杀黄弧菌、绿弧菌,而且不会对虾蟹造成伤害。

· 图五 微立旺消毒剂菌粉 ·

 水产健康生物解决方案 Aquatic Microbiota 水产功能微生物系统性应用研究
水产健康生物解决方案 Aquatic Microbiota 水产功能微生物系统性应用研究 作物健康生物解决方案 Agricultural microorganisms 农业功能微生物系统性应用研究
作物健康生物解决方案 Agricultural microorganisms 农业功能微生物系统性应用研究 动物健康生物解决方案 Animal microbiota 动物功能微生物系统性应用研究
动物健康生物解决方案 Animal microbiota 动物功能微生物系统性应用研究 人类健康与益生菌解决方案 Animal microbiota 以科学之力,打造卓越益生菌解决方案
人类健康与益生菌解决方案 Animal microbiota 以科学之力,打造卓越益生菌解决方案 医药生物解决方案 Animal microbiota 合成生物学正驱动生物医药跃迁
医药生物解决方案 Animal microbiota 合成生物学正驱动生物医药跃迁 青贮饲料解决方案 Animal microbiota 提高青贮饲料质量和生产
青贮饲料解决方案 Animal microbiota 提高青贮饲料质量和生产 微立旺简介 Aquatic Microbiota 一站式提供功能微生物源核心料服务商
微立旺简介 Aquatic Microbiota 一站式提供功能微生物源核心料服务商 愿景使命价值观 Aquatic Microbiota 聚焦用户价值持续创新功能微生物
愿景使命价值观 Aquatic Microbiota 聚焦用户价值持续创新功能微生物 发展历程 Agricultural microorganisms 累计服务企业超过3000+
发展历程 Agricultural microorganisms 累计服务企业超过3000+ 专家团队 Agricultural microorganisms 引进吸收全球前沿生物技术
专家团队 Agricultural microorganisms 引进吸收全球前沿生物技术 核心团队 Animal microbiota 科技型中小企业 国家高新技术企业
核心团队 Animal microbiota 科技型中小企业 国家高新技术企业 荣誉资质 Animal microbiota 产品销往世界10多个国家和地区
荣誉资质 Animal microbiota 产品销往世界10多个国家和地区 企业相册 Animal microbiota 源头厂家 货源充足 供货有保障
企业相册 Animal microbiota 源头厂家 货源充足 供货有保障 联系我们 Animal microbiota 一对一专业技术服务 保姆式售后服务
联系我们 Animal microbiota 一对一专业技术服务 保姆式售后服务

电话:136-8234-1316
电话:136-8234-1316 微信:13538246963
微信:13538246963 邮箱:yiqing@wlw13.cn
邮箱:yiqing@wlw13.cn 手机:13538246963
手机:13538246963 地址:广东省广州市天河区华南农业大学金慧路88
地址:广东省广州市天河区华南农业大学金慧路88






